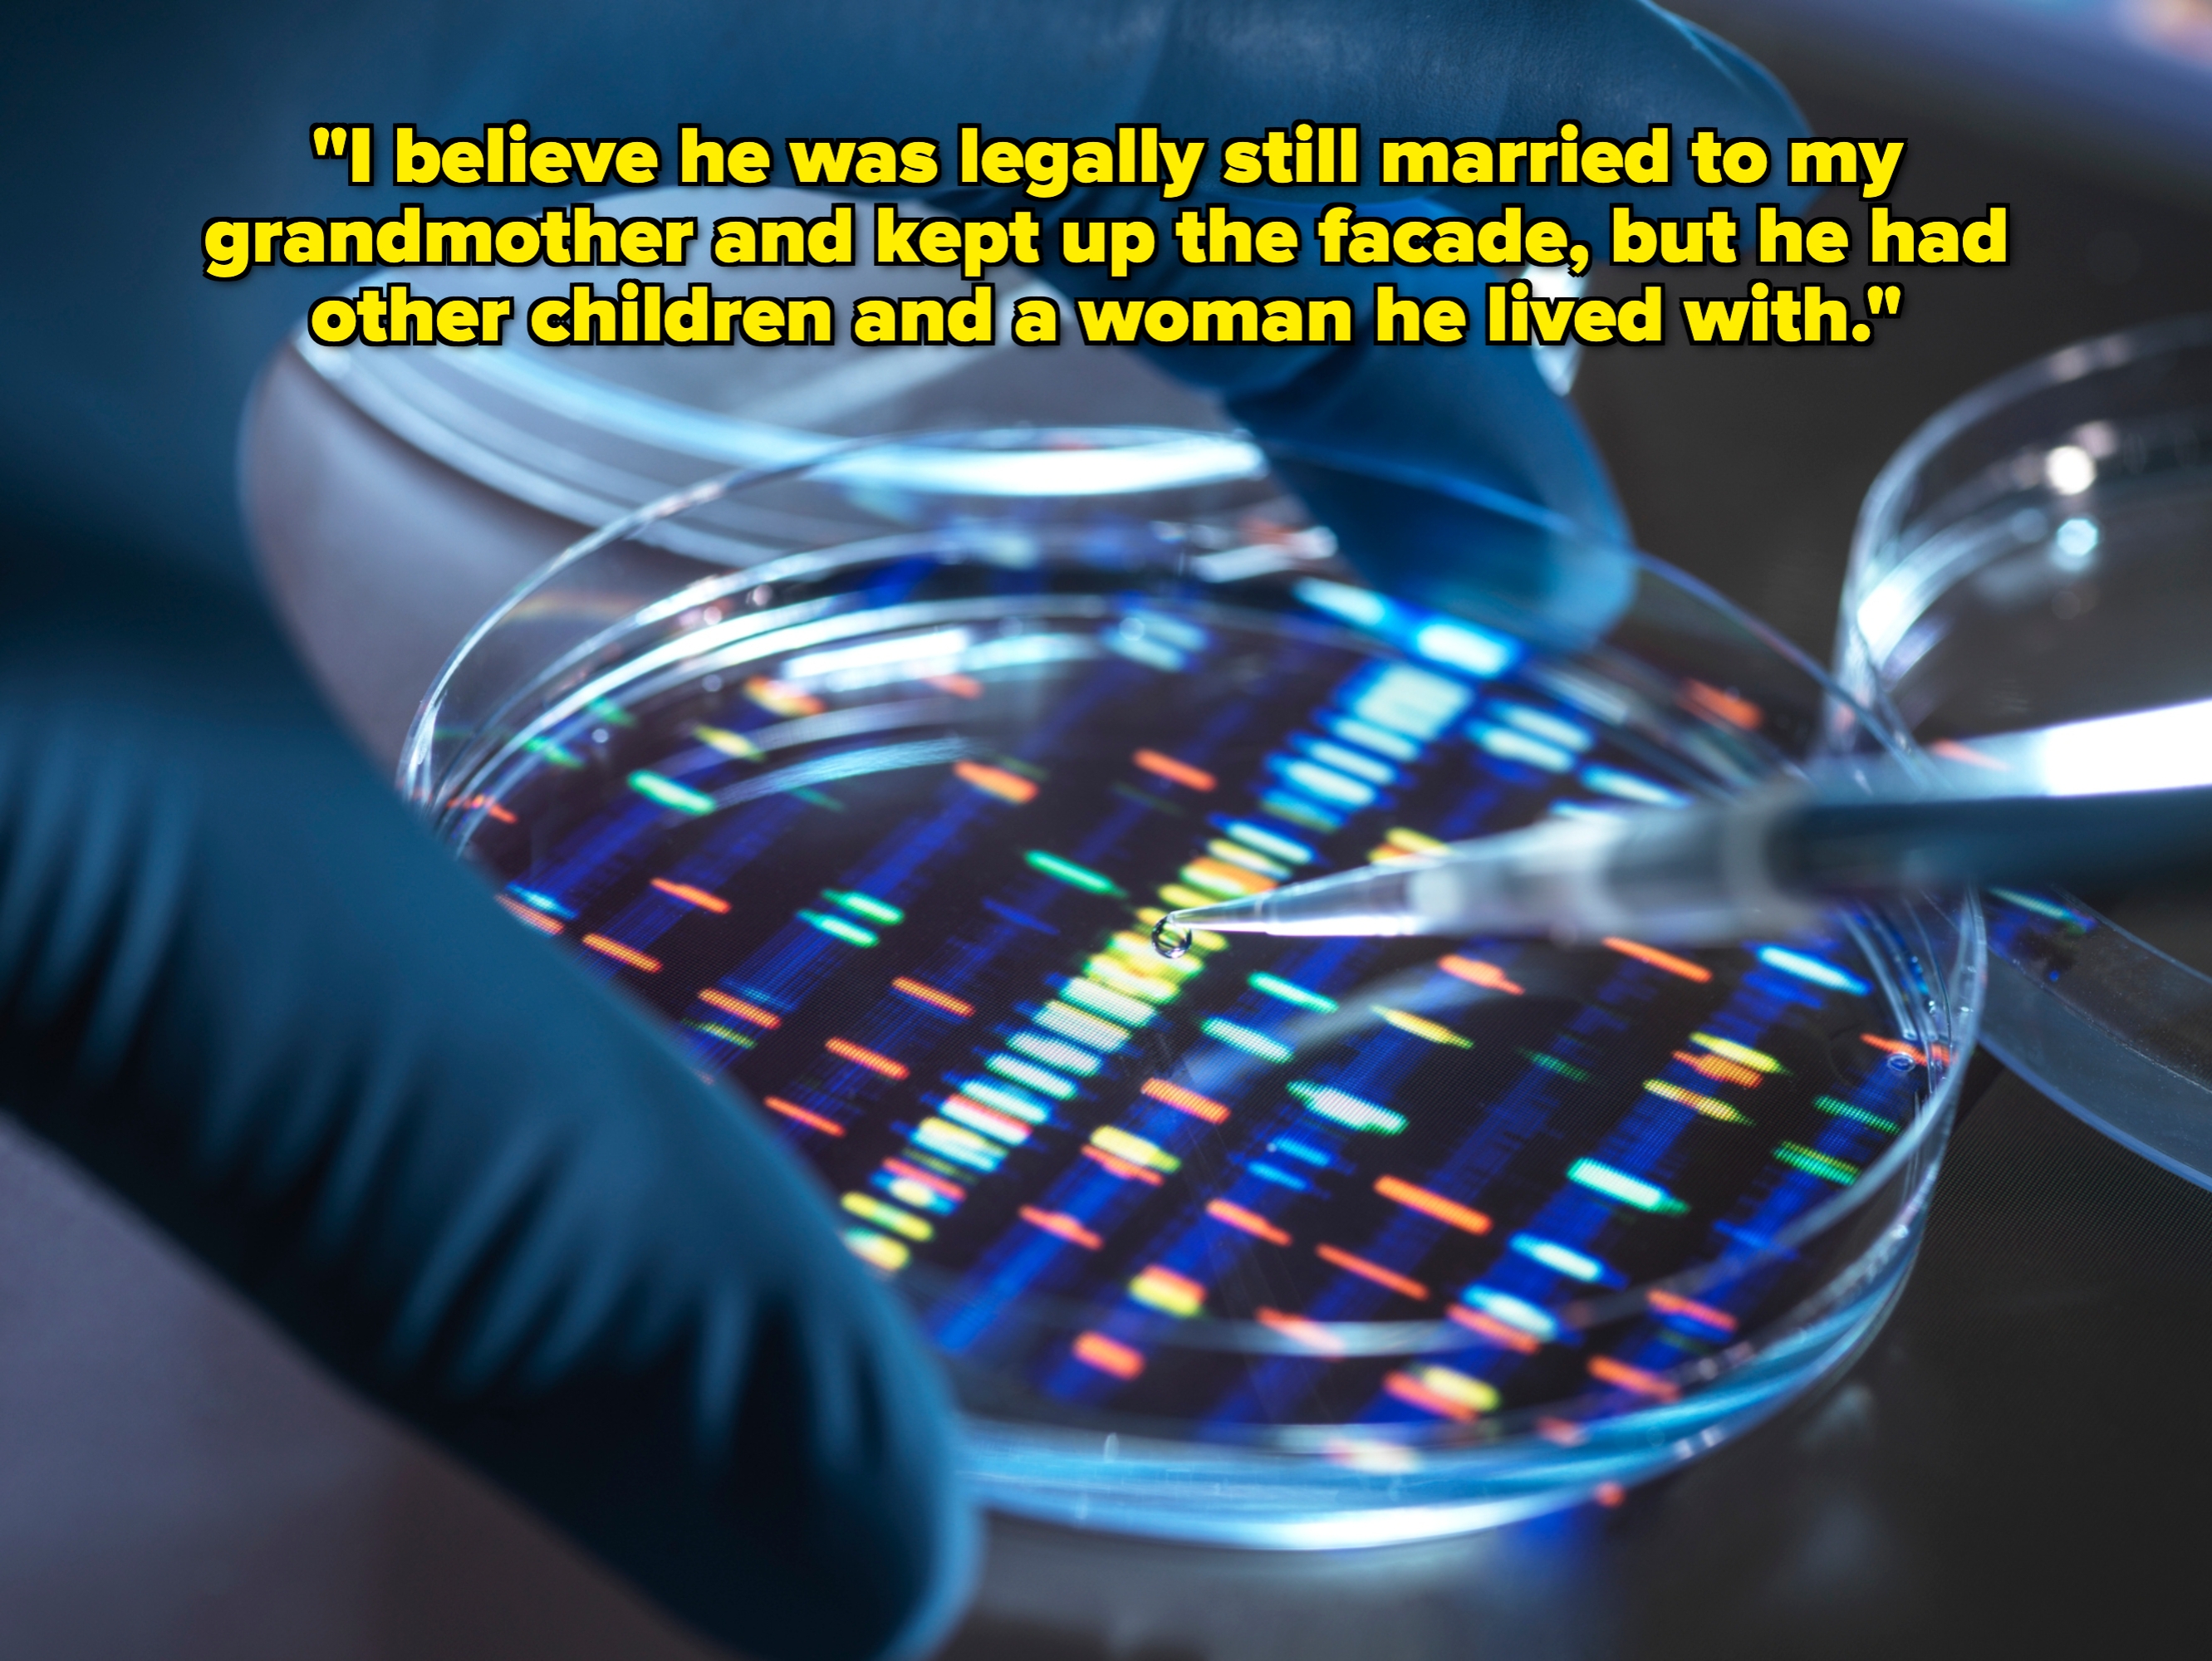
Gloved hands work with a pipette over a petri dish displaying a pattern, suggesting a scientific experiment or DNA analysis

" Yes , he was chisel on my grandmother the entire time she had cancer . "
We recentlyaskedmembers of theBuzzFeed Communityto tell us about the shocking or dark secrets their grandparents were keeping from the family. We also perused someRedditthreadsabout family secrets coming to light and came across even more stories of secretive (and sometimes sketchy) grandparents. Here’s what we uncovered:
1.“My great-granddad murdered a banker in Mustang, Oklahoma over a loan dispute. He changed his name and left his wife and kids. He went on the run on the railroads before settling down just north of where I live. He got remarried and had more children, one of them being my grandmother. He left a deathbed confession letter about the entire thing. Our family has a yearly reunion with his other family in Mustang. It’s pretty mind-blowing knowing I wouldn’t be here if he didn’t kill someone.”
— Ezmoney43
2.“On her deathbed, during her last few minutes of life, my grandmother confessed to our entire family, including my grandfather, that she had cheated with another man about 50 years ago for 25 years. She also confessed that she had both of her children, my mother and aunt, with the man she cheated with. My mother took a DNA test and confirmed that this was true. My grandfather, distraught with the fact that the kids he had raised were not his and he had no children, moved across the country and claimed that he didn’t want to be a part of the family anymore. This was years ago, and nobody in our family had heard anything until a few months ago when he sent an apology letter and claimed that he wanted to be a part of our lives again, even though it turned out that we weren’t related by blood.”
— Anonymous
3.“Grandma and Grandpa did love each other and were married but weren’t ‘together.’ Grandma was gay, and Grandpa was herbest friend. She wanted kids, so they had kids, but she had her love, ‘Auntie Doreen,’ we called her. Grandpa was free to do whatever he wanted and, to our knowledge, never had a dedicated partner besides my grandmother.”
— Eas_Mackenzie
4.“My grandma didn’t go to jail in the late ’80s for not paying taxes. She went to federal prison for distribution of cocaine. Apparently, she was a huge dealer and known as ‘Cocaine Granny’ locally for years before she sold to an undercover and got busted. I learned the truth from an older cousin when I was about 20. It happened when I was around 8.”
— ATLiensinyosockdraw
5.“My grandfather paid each of his three children to never again complain about the fact that he married his ‘mistress’ a month after my grandmother died of cancer. And yes, he was cheating on my grandmother the entire time she had cancer.”
— nonihongo
6.“My grandmother immigrated to North America from Europe in 1970 and did not leave Canada until she died in 2017. Until the day she died, everyone who knew her (family or otherwise) knew that she did not speak English, only her mother tongue. She couldn’t read, write, or drive and didn’t get out much. The majority of her life was spent indoors taking care of us grandkids before and after school and going to church (mass in her language). When she suffered a fall in 2007, she was hospitalized for a short time and given pain medication. My mother was with her in the hospital and left the room for a few minutes to grab a cup of coffee. When she came back, my drugged-up grandma was having an entire conversation in English with one of the medical staff. Perfectly fluent. I’m the only family member who knows anything other than my mom. The medical staff found it hilarious, though.”
" As soon as she sobered up from the painfulness meds , she adamantly denied it ever happen and stuck to that story for the next ten . "
— FlashingAppleby
7.“My grandmother was a Code Girl in Washington, DC during WWII (check out Liza Mundy’s book about the topic), and she didn’t tell ANYONE in the family. We didn’t find out until my aunt found her Naval Enlistment paperwork and her wartime journal in her desk after her death. She was part of a unit that cracked Pacific Theater communications, enabling success in the island-hopping work of the Navy. We found out from her journal that the women in the unit were taken to a Maryland church and had to swear under penalty of death that they wouldn’t share anything about their code-breaking work in the war. They were supposed to tell their families that they were just stenographers in the war department.”
" Then , after the war , they were shove out — no pension or public quotation of their piece of work — to become wives and mothers with their contributions everlastingly a arcanum . "
— Lightlylilly
8.“My grandpa didn’t want any of his grandchildren to know he went to jail for three or four years for fraud. The thing is, he was another victim of fraud. The guy he was doing business with (rent of agricultural machinery) used checks without funds and put all the machines in my grandpa’s name. The other guy left no trace of his actions in the whole business, so all the shit fell on my grandpa. He didn’t want us to know he went to jail. He thought it would ruin our image of him, even though he was innocent. Even after learning this postmortem, we still love him as much as we always did.”
— CompletoSinMayo
9.“My memaw and her father, along with all her kids and siblings (my mom included) were busted for the biggest underground meth lab anyone had seen in the US at the time. My memaw and her siblings spent quite a few years in federal prison for it, as well as her children (my mom included). Rumor has it there’s a body or two buried on the land, and a murder and attempted murder occurred on it as well. And that’s just the beginning!”
— mushypumpkin47
10.“My uncle was engaged to my godmother. They had been together for years. He got drafted into the services and was stationed in Bermuda. The plan was that he’d complete his two-year tour of duty, and my godmother would coordinate their wedding for when he got back. Six months after his deployment, the wedding was abruptly called off, and my uncle suddenly married another woman that no one in the family had met. Everyone was stunned. No one knew what happened, and my godmother disappeared from our lives. Years later, it was discovered that my grandfather seduced my godmother (a raging secret affair), and my uncle found out. It was a closely guarded secret until I was in my 50s. I still have no idea what happened to my godmother.”
11.“My father’s brother was killed by his stepfather in a ‘hunting accident’ because the child was not his. Oddly, the same thing happened to my wife’s older brother. Apparently, ‘hunting accidents’ were quite common in the ’60s.”
— goldensorcerer98
12.“My grandparents were extremely wealthy. I recently found out that a lot of that money was illegal profits from alcohol during prohibition (their parents and aunts had made the money) that was then legally invested for my grandparents to manage.”
— sparklysalt40
13.“My Dutch grandfather’s identity is protected in three countries. In Australia, it is restricted by ASIO for ‘international relations,’ ‘national security,’ and ‘the security of the Commonwealth.’ We cannot see any reason or explanation in the Netherlands or England. He was a potato farmer who fought in the resistance during WWII, came to Australia, lived a very humble life, and never spoke a word. ASIO said they will never release his record, so we have to accept it at this point.”
— cpops
14.“My grandfather had a whole other side family. People knew about it, but no one talked about it. I suspected something was up as a child because there were signs. He never arrived anywhere with my grandmother. I hardly ever saw him at their place. My mom told me when I was older. I believe he was legally still married to my grandmother and kept up the facade, but he had other children and a woman he lived with. When he died, I was curious if they would be at his funeral. But I never made it to the service because my daughter got very sick. I did 23andMe and Ancestry, thinking maybe I could find out more about them, but I haven’t come across anyone that I know of.”
15.“I’m adopted but was partially raised by my bio family. My step-grandma (an awful person) recently told me that when my bio mom was 13, she got pregnant by HER mom’s boyfriend. She later had an abortion, but they all blamed her, saying she was ‘fooling around’ when she shouldn’t have been. I hate that no one protected her, and everyone was against her.”
— grouchyswan78
16.“My Grandad, back in the ’50s, asked my Nana’s father for permission to marry her. He said no. One Friday after work, they went to the registrar and got married. Then Grandad returned to his house, and Nana returned to her parents' without saying anything. They kept it quiet for a few months until one night, Nana announced she was going home with Grandad. Her father said the equivalent of, ‘Like hell, you will!’ They confessed at that point. They were married for over 60 years until they passed away. We always knew there were no wedding photos and that they hadn’t had a party, but the full story didn’t come out until their 50th wedding anniversary party when one of their friends who acted as a witness to the marriage was reminiscing about it with my uncle, thinking we all knew the full story.”
" There was clearly absolute topsy-turvydom at this revelation ; not a undivided family member knew anything about this for 50 years . I ’m jolly sure that had the booster not said anything , my grandparent would have taken it to their grave without mentioning it to another animation soul . "
17.“My great-grandmother had a child with someone (no idea who) and a few years later met my great-grandfather. He proposed but said she would have to get rid of the kid before he would marry her. She agreed and brought the kid somewhere, to an orphanage, to their father or his family, no one knows. She came back, and they married and had three kids. She never talked about that first child again. It’s a huge mystery.”
— Idislikethis _
18.“My great-great-grandfather moved from Romania to America and married another Romanian immigrant shortly after he arrived. Once they married, he insisted they start using ‘American’ names, only speak English in public, never return to Romania, and refrain from communicating with family in the old country. When my great-grandmother (his daughter) was a teenager, it was discovered by the rest of the family that he actually abandoned his first wife and three children in Romania and left them in extreme poverty when he came to the States and married my great-great-grandmother. Ya know, real upstanding guy.”
— SilentBlizzard1
19.“My grandma had a darker complexion and beautiful black hair. She always said we were Hungarian andGreek. It turns out she was mostlyCreeand was sworn to secrecy. She did not tell us about any of this and apparently even kept it a secret from her husband, who passed before her. She never spoke about her family, and I feel like there is so much I don’t know. I have more questions than answers now.”
20.“My great-grandparents were high school sweethearts and the only role models I’d ever had for a relationship since my grandparents and parents are divorced and hate each other. Then my mom tells me that my great-grandma had an affair, and that’s why one of my grandma’s sisters isn’t like the others. So, there goes that.”
— Symnestra
21.“My grandparents on my mother’s side were swingers — all four of them. After my mother was born, her mother and father split up, and then each married a person from another couple. Sort of a marriage merge.”
— Saint_of_Stinkers
22.“My great-grandparents kept this secret. My great aunt (my grandpa’s sister) died in her early 20s (this was in the 1930s). My grandpa was told she cut her finger while peeling an apple, and it got infected; she got septic and died. Grandpa passed in the early 2000s, but just two months ago, I was perusing the Find A Grave website and found her death certificate. She died from complications from a self-induced abortion. It made me wonder if my grandpa ever even knew the truth about his sister. The more shocking part is that I texted a cousin of mine to tell her about my findings. She goes, ‘I don’t think that’s right. Pretty sure she died from getting an infected ingrown toenail.’ Turns out my great-grandparents were making different lies about this to each of their kids (you’d think it’s simpler to just stick to one lie, but whatever).”
" Meanwhile , her boyfriend found a newfangled lady friend , got wed , and inhabit normally just miles by from my great - grandparents . "
— thegassygoose
23.“Basically, my great-grandmother had a child at a very young age during the early ’40s and gave her up for adoption. We didn’t know until after my great-grandmother died in 2017. It wasn’t until last year my grandfather and the rest of his living siblings finally met her.”
— Weak_Carpenter_7060
24.“After my grandmother passed away, my grandfather told the family that she had once been hospitalized and treated with electric shocks for her depression. We had no idea about this, but it really explains a lot.”
— clicksherheels6126
25.“My grandma’s first husband kidnapped my uncle for three years when he was a toddler. She married my grandfather, who helped her get my uncle back.”
— Fn_up_adulting
26.“My granddad married and had my dad with his wife, only to then break up with her and marry her sister. I’ve never met my biological grandmother. I’m not even sure if she’s still alive. Everyone also seems to have kind of accepted this. Nobody really questions it. But I think it’s really weird and kind of messed up.”
— DanielSophoran
27.And: “My husband’s grandmother lied about her age for YEARS. She was embarrassed that she was a few years older than her husband. I guess this was a scandal back in the 1930s, so she shaved a few years off — even on her driver’s license. People from the rural South during that time didn’t have great birth records anyway, so she could do it. It caused major issues with her getting Social Security. It was nuts to me. I found out at her funeral.”
— Midlevelluxurylife
mention : Submissions have been edited for length and/or pellucidity .

Note: Submissions have been edited for length and/or clarity.